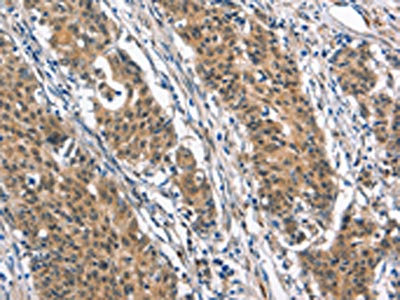

BNIP3L Antibody
-
中文名稱:BNIP3L兔多克隆抗體
-
貨號:CSB-PA570255
-
規(guī)格:¥1100
-
圖片:
-
The image on the left is immunohistochemistry of paraffin-embedded Human thyroid cancer tissue using CSB-PA570255(BNIP3L Antibody) at dilution 1/40, on the right is treated with synthetic peptide. (Original magnification: ×200)
-
The image on the left is immunohistochemistry of paraffin-embedded Human gastric cancer tissue using CSB-PA570255(BNIP3L Antibody) at dilution 1/40, on the right is treated with synthetic peptide. (Original magnification: ×200)
-
-
其他:
產(chǎn)品詳情
-
Uniprot No.:
-
基因名:
-
別名:Adenovirus E1B19k binding protein B5 antibody; Adenovirus E1B19K-binding protein B5 antibody; BCL2/adenovirus E1B 19 kd protein interacting protein 3a antibody; BCL2/adenovirus E1B 19 kDa protein interacting protein 3A antibody; BCL2/adenovirus E1B 19 kDa protein-interacting protein 3-like antibody; BCL2/adenovirus E1B 19 kDa protein-interacting protein 3A antibody; BCL2/adenovirus E1B 19kDa interacting protein 3 like antibody; BNI3L_HUMAN antibody; BNIP3a antibody; BNIP3H antibody; BNIP3L antibody; BNIP3L protein antibody; NIP3 like protein X antibody; NIP3-like protein X antibody; NIP3L antibody; NIX antibody
-
宿主:Rabbit
-
反應種屬:Human,Mouse
-
免疫原:Synthetic peptide of Human BNIP3L
-
免疫原種屬:Homo sapiens (Human)
-
標記方式:Non-conjugated
-
抗體亞型:IgG
-
純化方式:Antigen affinity purification
-
濃度:It differs from different batches. Please contact us to confirm it.
-
保存緩沖液:-20°C, pH7.4 PBS, 0.05% NaN3, 40% Glycerol
-
產(chǎn)品提供形式:Liquid
-
應用范圍:ELISA,IHC
-
推薦稀釋比:
Application Recommended Dilution ELISA 1:2000-1:5000 IHC 1:50-1:200 -
Protocols:
-
儲存條件:Upon receipt, store at -20°C or -80°C. Avoid repeated freeze.
-
貨期:Basically, we can dispatch the products out in 1-3 working days after receiving your orders. Delivery time maybe differs from different purchasing way or location, please kindly consult your local distributors for specific delivery time.
-
用途:For Research Use Only. Not for use in diagnostic or therapeutic procedures.
相關產(chǎn)品
靶點詳情
-
功能:Induces apoptosis. Interacts with viral and cellular anti-apoptosis proteins. Can overcome the suppressors BCL-2 and BCL-XL, although high levels of BCL-XL expression will inhibit apoptosis. Inhibits apoptosis induced by BNIP3. Involved in mitochondrial quality control via its interaction with SPATA18/MIEAP: in response to mitochondrial damage, participates in mitochondrial protein catabolic process (also named MALM) leading to the degradation of damaged proteins inside mitochondria. The physical interaction of SPATA18/MIEAP, BNIP3 and BNIP3L/NIX at the mitochondrial outer membrane regulates the opening of a pore in the mitochondrial double membrane in order to mediate the translocation of lysosomal proteins from the cytoplasm to the mitochondrial matrix. May function as a tumor suppressor.
-
基因功能參考文獻:
- The results demonstrate that Nix can serve as an alternative mediator of mitophagy to maintain mitochondrial turnover, identifying Nix as a promising target for neuroprotective treatment in PINK1/Parkin-related Parkinson's disease. PMID: 28281653
- Here the authors present evidence for phosphorylation-driven regulation of the Nix:LC3B interaction. Isothermal titration calorimetry and NMR indicate a ~100 fold enhanced affinity of the serine 34/35-phosphorylated Nix LC3-interacting region (LIR) to LC3B and formation of a very rigid complex compared to the non-phosphorylated sequence. PMID: 28442745
- p75(NTR) and NIX may play critical roles in intracerebral hemorrhage-induced neuronal apoptosis in vitro and in vivo. PMID: 27726026
- Data suggest that targeting BNIP3L protein in wild-type p53 tumor suppressor colon cancer cells is an anticancer strategy activating iron depletion signaling and the mitophagy-related cell death pathway. PMID: 26517689
- regulates mitophagy during hypoxia, whereas NIX is required for mitophagy during development of the erythroid lineage. PMID: 25753537
- Nix protein positively regulates NF-kappaB activation in gliomas PMID: 22984526
- mitochondrial ROS and NIX are essential factors for Mieap-induced accumulation of lysosome-like organelles within mitochondria PMID: 21264228
- Nix functions as an autophagy receptor, which mediates mitochondrial clearance after mitochondrial damage and during erythrocyte differentiation PMID: 20010802
- NIX binds to TSAP6 in tumor cells and has a role in apoptosis PMID: 12606722
- The proapoptotic factor Nix is a highly regulated effector of growth during terminal erythroid maturation. PMID: 12663450
- Bnip3L, capable of attenuating tumorigenicity, mediates p53-dependent apoptosis under hypoxia. PMID: 15607964
- NIX is required for the selective elimination of mitochondria, however, because mitochondrial clearance, in the absence of NIX, is arrested at the stage of mitochondrial incorporation into autophagosomes and autophagosome maturation. PMID: 18048346
- Homozygous deletions in a number of biologically important genes were found in prostate cancer cell lines, including PPP2R2A and BNIP3L identified in this study. PMID: 18670647
顯示更多
收起更多
-
亞細胞定位:Nucleus envelope. Endoplasmic reticulum. Mitochondrion outer membrane. Membrane; Single-pass membrane protein. Note=Colocalizes with SPATA18 at the mitochondrion outer membrane.
-
蛋白家族:NIP3 family
-
數(shù)據(jù)庫鏈接:
Most popular with customers
-
-
YWHAB Recombinant Monoclonal Antibody
Applications: ELISA, WB, IHC, IF, FC
Species Reactivity: Human, Mouse, Rat
-
-
-
-
-
-